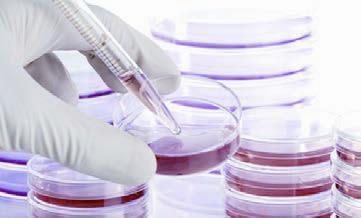

中法海洋卫星发射成功!我国启动“天河工程”星箭研制!
中法海洋卫星发射成功!我国启动“天河工程”星箭研制!

中法海洋卫星发射成功
2025年10月29日8时43分,中法两国共同研制的首颗卫星——中法海洋卫星从中国酒泉卫星发射中心升空,首次实现海风海浪同步观测。这次发射,将我国发射的海洋卫星和海洋作为牵头主用户的卫星数字改写为7颗。到2025年,我国计划再发射14颗卫星,其中7颗海洋卫星立项在研,即将形成全球海洋水色、海洋动力环境观测和海洋监视监测能力。

我国启动“天河工程”星箭研制
2025年11月6日,我国已正式启动“天河工程”卫星和火箭工程研制,“天河工程”卫星模型在第十二届中国国际航空航天博览会上首次公开亮相。据天河卫星总指挥刘伟亮介绍,“天河工程”卫星和火箭工程由中国航天科技集团八院总研制,计划于2025年完成“天河一号”卫星首批双星发射。

蓋亚望远镜数据揭秘银河系成因
2025年11月1日,欧洲科学家团队通过盖亚望远镜发布的数据,确定了我们所在银河系的形成原因——大约100亿年前,银河系与另一个星系碰撞,导致银河系银晕内充满了恒星,并且使银盘增厚,而这个相撞的星系也因此次发现被命名。研究团队根据盖亚望远镜和巨人恩克拉多斯(希腊神话里面的盖亚之子),将这个撞击星系命名为“盖亚—恩克拉多斯”。

我国大科学装置“上海光源”首条光束线站顺利出光
2025年11月2日,我国大科学装置“上海光源”首条光束线站——硬X射线通用谱学线站完成首轮调试,同步辐射光顺利到达实验站,标志着“上海光源”线站工程正式进入调试出光阶段。硬X射线通用谱学线站全部由“上海光源”设计、国内自主加工完成。下一步,科研人员将不断优化线站参数,使线站尽快达到验收指标。“上海光源”线站工程将按照计划于2025年12月竣工完成。

“雪龙”号穿越“第四极”马里亚纳海沟
2025年11月7日,“雪龙”号极地科考船通过有着地球“第四极”之称的世界最深海沟——马里亚纳海沟洋面,向南极行进。“雪龙”号通过的海域位于海沟最深处的西面。根据海图,马里亚纳海沟最深处水深10 924米。目前“雪龙”号正以15节(1节等于1.852千米)左右的时速行进,11月9日通过赤道,从北半球进入南半球,继续向南极挺进。

3D器官芯片可实时监测细胞活动
2025年11月3日,英国剑桥大学研究人员开发出一种三维(3D)器官芯片,可实时监测细胞活动,有望用于开发新疗法,同时减少研究中实验动物的使用数量。新设备可以成为多种类型的器官芯片,如肝脏芯片、心脏芯片等,最终得到“身体芯片”,可以模拟各种治疗方法对整个身体的影响。

我国学者发现低温等离子体杀伤癌细胞的“攻防机制”
等离子体被认为是固体、液体、气体之外物质存在的“第四态”,近年来在生物医学领域显示出广阔应用前景。2025年10月25日,中科院合肥物质科学研究院在大气压低温等离子体治疗肿瘤方面取得新进展,发现了等离子体杀伤癌细胞的机制,以及癌细胞的“抵御”机制,对抗癌的疗效预判、提高具有重要指导意义。

机器学习可预测基因组修复结果
2025年11月8日,美国布列根和妇女医院及哈佛医学院科学家理查德·舒尔伍德及同事,发明了一种用机器学习预测基因组修复结果的方法,可通过机器学习对致病基因变异实现精准且可预测的编辑。这项成果为研究遗传疾病,开发潜在疗法提供了新的可能性。
标签:

104
女士项链品牌排行榜前十名(首饰前十名品牌排行榜) 蒂芙尼 蒂芙尼是美国珠宝品牌,有多种珠宝系列,其中最经典的T系列是最受欢迎的,也是标志性品牌符号恒久经典。如果一辈子...

118
铅笔道影响力再创新高:217.17万,最高330万_ZAKER新闻 8 月 15 日消息,据微信指数显示,铅笔道单日影响力达突破 217.17 万,再创新高,打入科技创新创业媒体的领军阵容。 微信指数是腾...

109
幼猫发出嗡嗡嗡像马达的声音怎么回事(发出低沉咕噜咋办) 猫一直发出低沉的马达声,小猫一碰它就咕噜咕噜! 铲屎官们在饲养猫咪的时候经常会发现一个普遍的现象,自己家的小...

131
中方再次敦促美方立即停止无端盘查滋扰中国留学生 近几个月来,中国赴美国留学人员遭美方边境执法人员无端盘查、滋扰、甚至被注销签证遣返回国的情况愈演愈烈。中国驻美国大使...

77
月季黄叶黑斑怎么处理最好(月季叶子有黑斑掉叶怎么补救) 家里养的月季老是有黑斑,叶子经常发黄掉落,要怎么彻底解决? 黑斑病是月季花特常见的病害,可以说只要养过月季花...
133
女高中生结识“菩萨转世”遭PUA七年,被拍不雅视频、骗家里卖房损失超百万 遇到转世的文殊菩萨 只有不断满足对方的需求 才能赎清前世欠下的债 …… 这套听来颇有些荒诞的说辞 却...

176
中国著名十大肛肠医院的简单介绍 本文目录一览: 1、上海治疗肛肠的医院哪家最好?肛门痒怎么办?2、北京最好的肛肠医院是哪家?3、求北京最好的肛肠医院及专家4、北京市最好的肛肠...

71
中国十大雅事文人(中国古代文人雅集) 本文目录一览: 1、古代十大雅事2、中国十大雅事3、中国古人十大雅事4、十大雅事分别是什么 古代十大雅事 焚香 古人焚香是为了享受高雅,...

129
为什么中国网民看不起印度:看看老百姓的生活你就知道! 下面这段视频,是 @我是郭杰瑞 在印度拍的一段视频之一。 他在价值千万美元的1500平米豪宅里,采访了一位有美国成长背景...

160
有人建议广东再建一所医科大学,官方婉拒,网友认为这是出馊主意 最近有人在人民网给领导留言建议,汕头市以汕头大学医学院为基础成立汕头医学院或者是汕头医科大学,实现独立...

104
“妇女”的法律定义是什么?那些与你常识理解不一致的法律术语 1、妇女 妇女在司法解释中定义是14岁以上的女性,未满14岁的男女称为儿童。并非人们通常认为的成年女子或者是“非...
145
两院院士,科技大牛,工资待遇却像个放牛的 近期一张中国科学院院士的照片上了热搜,说是院士汪景琇在参加完中科院的会议后,独自背着背包挥手离去,没有专车接送。穿着上极其...

141
邓超和工作室互怼,因被纠正四十一岁工作室解散,工作室回应更绝 在娱乐界,邓超一直是一个非常有趣的角色,当然,这更多是因为他的个性。当他参加男性跑步表演时,总是对气氛...

63
高通骁龙778g相当于联发科什么水平(高通骁龙778g属 于什么级别) 骁龙778g相当于麒麟多少? 骁龙778g自发售之后就顶着荣耀数字这个系列强势出现,这让很多小伙伴也是第一次听说高通家...

195
十大丑明星(十大吸毒明星) 林志玲 林志玲曾在节目中坦言自己不喜欢吸烟喝酒,但是被媒体曝光过吸毒的照片。虽然她对此事进行了否认,但是已经对她的形象造成了不小的影响。 张...

152
西塘古镇在哪里(浙江西塘古镇的具体位置及旅游攻略) 西塘古镇位于浙江省嘉兴市嘉善县,离嘉善县城11公里,是一座有着近千年历史的江南古镇。西塘古镇曾用名斜塘,是古代吴越...

198
盘点当年那些女神:叶子楣:演艺生涯与性感身材的完美融合 叶子楣,这个名字在香港演艺圈中具有极高的知名度。她以其出色的演技和性感的身材,赢得了无数观众的喜爱和认可。在...

193
数学课堂如何提高效率(十点做法心得) 1.问题是数学的心脏。要学好数学,离不开提问和解题。其实解题说白了就是用所学知识来解决问题。 2.制定课堂规则,让学生知道什么是可以...

173
韩国新生代偶像金路云 金路云,1996年8月7日出生于韩国,韩国男歌手、演员,男子舞蹈组合SF9成员。2015年,以练习生身份参加FNC日本家族演唱会;16日,金路云通过FNC Entertainment旗下的...

109
袁隆平贡献有哪些(袁隆平世界贡献有哪些) 袁隆平生平事迹简介:袁隆平,1930年出生于北平,1935年毕业于西南农学院。1964年开始研究杂交水稻,1973年实现三系配套,1974年育成第一个...